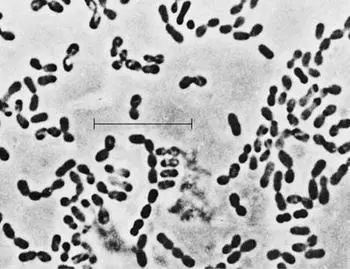
明串球菌属

明串球菌属
编辑明串球菌属是明串球菌科的革兰氏阳性菌属,属于乳杆菌目(乳酸菌)。 明串球菌属广泛存在于自然环境中,在各种工业和食品发酵中发挥着重要作用。
特点
编辑外观
大多数种类在液体培养中表现为球菌:细胞形状为圆形至椭圆形。 这些细胞单独存在,如双球菌和短链球菌。 它们在革兰氏染色中呈革兰氏阳性,没有主动运动的鞭毛,并且不形成持久形式,如内生孢子。 它们在光学显微镜下的外观类似于乳球菌属的代表,然而,球菌典型的球形细胞在明串球菌属中并不占优势,而是可以观察到椭圆形或卵形(“蛋形”)细胞形状。
生长与代谢
作为乳酸菌的典型代表,它们厌氧但耐氧生长,也就是说,它们在大气氧气存在的情况下生长,但不需要氧气来进行新陈代谢。 它们是过氧化氢酶阴性和氧化酶阴性。 然而,当它们在含有血亚胺或血液的培养基上培养时,它们能够形成细胞色素。 在这种情况下,它们会在氧化酶测试中显示出阳性反应。 此外,乳酸菌的一个典型特征是在培养过程中需要复杂的生长因子和氨基酸。
在需氧、厌氧和微需氧条件下进行异型发酵乳酸发酵。 D-葡萄糖或D-果糖通过磷酸戊糖途径转化为等摩尔量的D-乳酸、乙醇和二氧化碳。 只有该属的少数物种能够以这种方式分解乳糖(乳糖)。 为此,在细菌自身的β-半乳糖苷酶的帮助下,二糖乳糖被分解成葡萄糖和半乳糖两种成分。 另一方面,L-阿拉伯糖、D-甘露糖和麦芽糖属于大多数明串球菌属物种可以利用的碳水化合物。
所有物种也可以分解蔗糖,典型的是从底物蔗糖形成葡聚糖。 通过葡聚糖的形成,含蔗糖的溶液可以转化为果冻状物质。 形成的多糖葡聚糖作为所谓的粘液积聚在细胞周围。 如果明串球菌属物种在含蔗糖的固体培养基上培养,它们会形成大而粘稠的菌落,而在含葡萄糖的培养基上它们会生长为小菌落,不会形成粘液。
其他代谢途径涉及将乙酰辅酶 A 转化为乙偶姻和丁二酮,后者作为乳酸食品生产中的调味剂很重要。
MRS 培养基用于培养这些细菌,以液体形式(MRS 肉汤)或添加琼脂作为固体营养培养基。 它不是选择性营养培养基,但为所有乳酸菌提供了合适的营养范围,因为它除了葡萄糖外还含有肉膏、酵母膏、蛋白胨和各种矿物质。 孵化的最佳温度约为 30 °C。
明串球菌属的成员可以耐受高水平的葡萄糖而不影响它们的生长。 与嗜渗酵母相似,它们可以在水分活度低的环境中繁殖。 在本文中,细菌被称为耐旱细菌。 明串球菌属物种生长在含有 30-40% 葡萄糖的培养基中,因此具有耐旱性。
出现次数
编辑牛奶是许多明串球菌属物种的自然栖息地。 明串球菌属肠系膜可以从许多植物表面分离出来,既有完整的也有分解的。 天然存在于白菜上的明串球菌属种常参与酸菜的生产,1992年从酸菜中分离出的一株菌株被鉴定为新种。
含义
编辑其他物种参与青贮饲料和酸菜的生产,其中乳酸发酵也很重要。 许多不同的微生物参与咖啡豆的发酵,2007年的研究表明,明串球菌属也参与其中,并导致发现了一个新物种。明串球菌属物种也可以破坏生命如果不需要乳酸的形成。 除了鲜奶因“变酸”而变质外,真空包装的肉类和香肠产品也受到影响,因为细菌可以在厌氧条件下在那里生长。 这同样适用于在保护气体气氛(如二氧化碳)下包装的产品。在免疫功能低下的患者中,明串球菌属物种可引起菌血症和腹腔脓肿。
系统
编辑外部系统学
明串球菌属在细胞外观方面类似于乳球菌属的代表。 这两个属的 DNA 组成也有相似之处。 细菌 DNA 中的 GC 含量(核碱基鸟嘌呤和胞嘧啶的比例)为 38-41 摩尔百分比。 然而,它们的代谢不同,因为明串球菌属进行异型发酵乳酸发酵,而同型发酵乳酸发酵是典型的乳球菌属。
内部系统学
该属包括许多种。细菌的分类会定期更改,因为新的研究结果需要不同的分类或发现和描述新物种。
除了遗传学研究外,代谢-生理学特征还表明,对明串球菌属的归属尚无定论。 果杆菌物种不产生乙醇,乙醇是异型发酵乳酸发酵的典型代谢产物。 相反,它们将葡萄糖分解成乳酸和乙酸。 扫描电子显微镜下的图片也显示出杆状细胞。
内容由匿名用户提供,本内容不代表vibaike.com立场,内容投诉举报请联系vibaike.com客服。如若转载,请注明出处:https://vibaike.com/358527/
